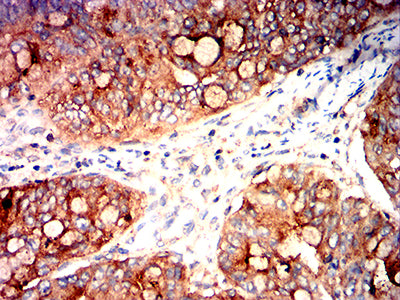
CD317

相关产品推荐更多 >
万千商家帮你免费找货
0 人在求购买到急需产品
- 详细信息
- 技术资料
- 免疫原:
peptide
- 亚型:
IgG2a
- 形态:
Liquid
- 保存条件:
-20℃
- 克隆性:
mAb
- 适应物种:
Human
- 保质期:
1年
- 目录编号:
TD-32100
- 级别:
科研级
- 库存:
88
- 供应商:
武汉天德
- 宿主:
Mouse
- 应用范围:
FCM、ELISA、IHC、ICC
- 靶点:
详询
- 抗体英文名:
Mouse Monoclonal Antibody to CD317
- 抗体名:
CD317
- 规格:
100ul/50ul
| 规格: | 100ul | 产品价格: | ¥2180.0 |
|---|---|---|---|
| 规格: | 50ul | 产品价格: | ¥1280.0 |
Mouse Monoclonal Antibody to CD317
Description |
|
| Bone marrow stromal cells are involved in the growth and development of B-cells. The specific function of the protein encoded by the bone marrow stromal cell antigen 2 is undetermined; however, this protein may play a role in pre-B-cell growth and in rheumatoid arthritis. | |
Specification |
|
| Aliases | BST2; TETHERIN |
| Entrez GeneID | 684 |
| Swissprot | Q10589 |
| clone | 7H2G12 |
| WB Predicted band size | 19.8kDa |
| Host/Isotype | Mouse IgG2a |
| Antibody Type | Primary antibody |
| Storage | Store at 4°C short term. Aliquot and store at -20°C long term. Avoid freeze/thaw cycles. |
| Species Reactivity | Human |
| Immunogen | Purified recombinant fragment of human CD317 (AA: extra 49-161) expressed in E. Coli. |
| Formulation | Purified antibody in PBS with 0.05% sodium azide |
Application |
|
| IHC | 1/200 - 1/1000 |
| ICC | 1/100 - 1/500 |
| FCM | 1/200 - 1/400 |
| ELISA | 1/10000 |
Product Image |
|
|
|
|
|
|
风险提示:丁香通仅作为第三方平台,为商家信息发布提供平台空间。用户咨询产品时请注意保护个人信息及财产安全,合理判断,谨慎选购商品,商家和用户对交易行为负责。对于医疗器械类产品,请先查证核实企业经营资质和医疗器械产品注册证情况。
 技术资料
技术资料暂无技术资料 索取技术资料
CD317
¥1280 - 2180